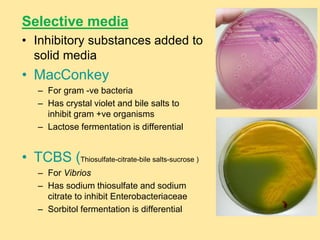
Selective media
• Inhibitory substances added to
solid media
• MacConkey
– For gram -ve bacteria
– Has crystal violet and bile salts to
inhibit gram +ve organisms
– Lactose fermentation is differential
• TCBS (Thiosulfate-citrate-bile salts-sucrose )
– For Vibrios
– Has sodium thiosulfate and sodium
citrate to inhibit Enterobacteriaceae
– Sorbitol fermentation is differential
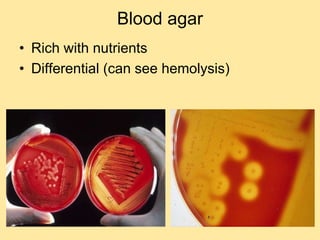
Blood agar
• Rich with nutrients
• Differential (can see hemolysis)
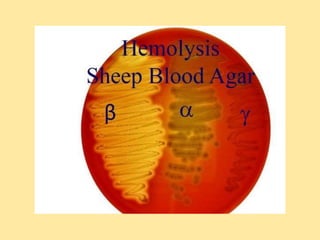
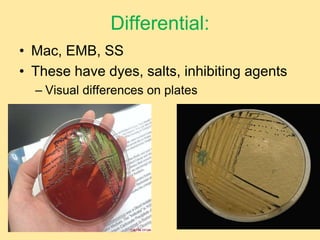
Differential:
• Mac, EMB, SS
• These have dyes, salts, inhibiting agents
– Visual differences on plates
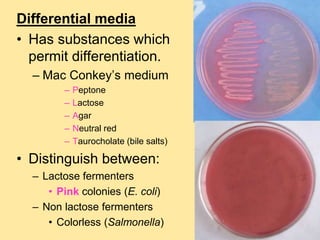
Differential media
• Has substances which
permit differentiation.
– Mac Conkey’s medium
– Peptone
– Lactose
– Agar
– Neutral red
– Taurocholate (bile salts)
• Distinguish between:
– Lactose fermenters
• Pink colonies (E. coli)
– Non lactose fermenters
• Colorless (Salmonella)
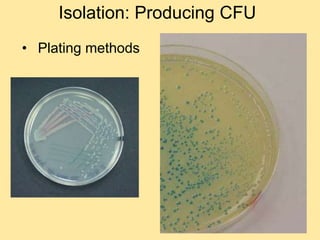
Isolation: Producing CFU
• Plating methods
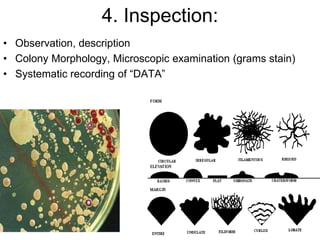
4. Inspection:
• Observation, description
• Colony Morphology, Microscopic examination (grams stain)
• Systematic recording of “DATA”
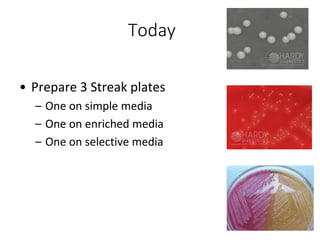
Today
• Prepare 3 Streak plates
– One on simple media
– One on enriched media
– One on selective media

The document discusses various microbiology techniques for culturing microbes including inoculation, isolation, incubation, inspection, and identification. It describes how to produce pure cultures through methods like streak plating and describes different types of culture media including solid, liquid, enriched, selective, and differential media. The goals are to transfer microbes to produce isolated colonies, grow them under proper conditions, observe characteristics, and identify organisms through comparing data.